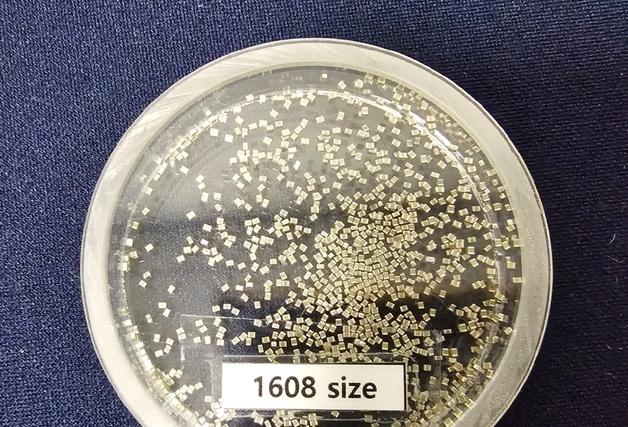

올해 D램 출하량 절반 이상, 데이터센터 수요 대응
전 세계적으로 출하되는 디램(D램)의 과반이 데이터센터에 사용되는 것으로 나타났다. 인공지능(AI) 산업 팽창으로 디램(D램) 수요가 종전 모바일, PC에서 데이터센터 중심으로 이동한 셈이다.29일 글로벌 시장 조사업체 카운터포인트리서치의 메모리 트래커에 따르면 2026년 전체 D램 출하량 중 48%가 서버용 D램, 9%가 HBM용으로 사용되고 있는 것으로 조사됐다. 이 두 항목을 합치면 전체 D램 출하량의 57%가 데이터센터 관련 수요에 대응